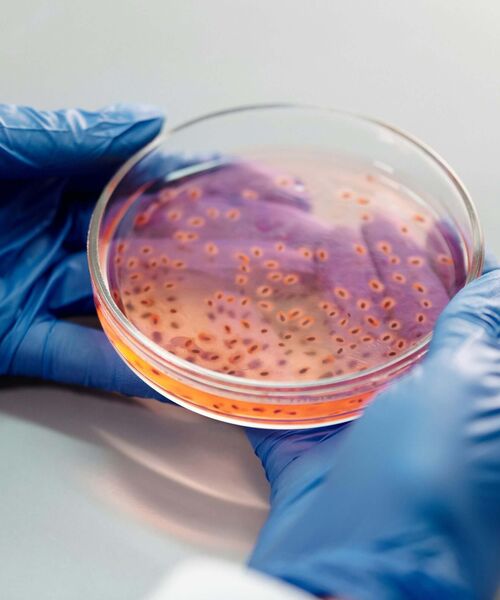

Wir beraten Sie gerne persönlich zu Ihrem Wunschstudium.
Schneller Überblick
Studienbeginn
01. Oktober
Studienform / -dauer
Vollzeit / 4 Semester
Studiengebühr
695 Euro / Monat
Einschreibegebühr
Einmalig 100 Euro
Praxis
Internes Forschungspraktikum, Externes Forschungspraktikum, Zusätzlich hoher curricularer Praxisanteilwährend des gesamten Studiums
Abschluss
Master of Science
(Fachhochschulabschluss)
Einsatzgebiete
› Pharmaindustrie, Labore, Medizintechnische Unternehmen, Biotechnologische Unternehmen, Forschungseinrichtungen, Hochschulen und Universitäten
Studium
Internationale Forschungskompetenz
Die Biomedizin ist ein globales Wissenschaftsfeld – und genau darauf bereitet Sie unser Masterstudiengang optimal vor. Durch die enge Einbindung in aktuelle Forschungsprojekte der HMU und die Kombination aus modernsten Methoden, fundierter Theorie und intensiver Praxiserfahrung entwickeln Sie eine wissenschaftliche Expertise, die international gefragt ist. Sie gewinnen Sicherheit in der internationalen Wissenschaft, erweitern Ihr Netzwerk und schaffen die besten Voraussetzungen, um Ihre Forschungskarriere über Ländergrenzen hinweg erfolgreich fortzusetzen.
Für wen ist der Master geeignet?
Das Masterstudium Biomedizin richtet sich an Absolvent:innen naturwissenschaftlicher Bachelorstudiengänge wie Biomedizin, Biologie, Biochemie, Molekularbiologie, Biotechnologie oder verwandten Disziplinen. Zudem ist er geeignet für Studieninteressierte mit medizinischem oder gesundheitswissenschaftlichem Hintergrund, die ihre Kenntnisse in molekularen und zellbiologischen Methoden vertiefen möchten, sowie für Forschende, die eine wissenschaftliche Qualifikation auf Masterniveau anstreben.
Studieninhalte
Der Masterstudiengang Biomedizin verbindet Naturwissenschaften, Medizin, Bioinformatik und moderne Technologien mit wissenschaftlichen und überfachlichen Kompetenzen. Inhaltlich beschäftigen Sie sich u.a. mit:
- biochemischen, biomedizinischen und mikrobiologischen Theorien und Methoden
- Pathophysiologie und Krankheitslehre
- Gentechnik und Laborsicherheit
- Ethik und Tierversuchskunde
- Analyse und Interpretation komplexer biomedizinischer Daten
- interne und externe Laborpraktika
Unser Fokus: Vernetzung auf mehreren Ebenen
Neben der Integration naturwissenschaftlicher Disziplinen und einer durchgängigen Verzahnung von Theorie und Praxis – jedes theoretische Modul ist inhaltlich an ein praktisches Modul gekoppelt – setzt der Masterstudiengang Biomedizin zusätzlich auf:
- Vermittlung wissenschaftlicher Querschnittskompetenzen in den Bereichen Ethik, Informatik und Recht
- interprofessionelle Zusammenarbeit durch gemeinsame Wahlpflichtmodule mit Studierenden der Humanmedizin, , Psychologie und anderen Studiengängen
- Integration aktueller Technologien (z.B. CRISPR/Cas, Proteomics und Bioinformatik)
- Kooperationen mit Forschungseinrichtungen und Industriepartnern für die externen Praktikumsmodule
Studienaufbau

Zulassung
Zulassungsvoraussetzungen auf einen Blick:
- Berechtigung zum Studium in Masterstudiengängen gemäß § 9 (5) BbgHG
- erfolgreich abgeschlossenes naturwissenschaftliches Bachelorstudium in Biomedizin, Biologie, Biochemie, Molekularbiologie, Biotechnologie oder verwandten Disziplinen oder erfolgreich abgeschlossenes medizinisches oder gesundheitswissenschaftliches Erststudium
Perspektiven
Ihre Karriere in der Biomedizin
Absolvent:innen des Masterstudiengangs Biomedizin arbeiten erfolgreich
- in der Grundlagenforschung
- in der angewandten Forschung und Entwicklung
- im Qualitätsmanagement
- in der biomedizinischen Industrie
Zudem bietet der Master of Science Biomedizin die Voraussetzung für eine naturwissenschaftliche Promotion.
Biomedizin steht für:
- Innovative Forschung an der Schnittstelle von Naturwissenschaft und Medizin
- Tiefes Verständnis für molekulare, zelluläre und organische Prozesse
- Hypothesen entwickeln, Experimente planen und aus Daten neue Erkenntnisse gewinnen
Lernen Sie die HMU und den Studiengang kennen
Infoveranstaltungen

Lernen Sie unsere Studiengänge bequem von zu Hause aus kennen.
Offener Campustag

Lernen Sie unseren Campus und uns kennen.
Informationsmaterial

Informationsmaterial zum Wunschstudium